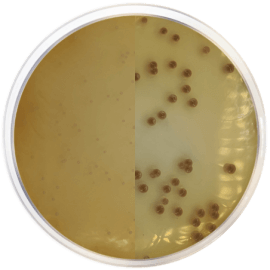
main product photo

Close
Chromogenic Agar Burkholderia Cepacia 500 grams/bottle
SKU
CDL/2142
Brand
CONDALAB
Pre-order (Deliver in 8 to 12 weeks)
Chromogenic Agar Burkholderia Cepacia is a selective medium specially formulated for the isolation amd detection of Burkholderia cepacia.
Burkholderia cepacia is a bacterial species of rising importance in the pharmaceutical, OTC and cosmetic industries in recent years.
Burkholderia cepacia is a Gram-negative, oxidase positive, mobile and aerobic bacillus. It is normally found in water deposits and damp environments. This bacillus is an important opportunist pathogen and causes pulmonary infections in Cystic Fibrosis patients. The organism may be present in small numbers in many non sterile products used in hospitals. It has been isolated from a number of water sources and can grow in distilled water with a nitrogen source because of its capacity to fix CO2 from air.
The medium contains peptone, which provides nitrogen, vitamins, minerals, and amino acids essential for growth. Yeast extract is a source of vitamins, particularly of the B-group. Selective agents are added to improve B. cepacia recovery through the inhibition of common contaminants. Chromogenic
substrate is added to detect B. cepacia by means of a color change in its colonies. Bile salts inhibit most Gram-positive cocci except for enterococci.
Sodium pyruvate increases the recovery of stressed cells. Tween 80 and soya lecithin neutralize quaternary ammonium compounds and parahydroxy benzoates. Magnesium sulphate, ammonium sulphate, and ferroammonium citrate provide sources of sulfates and metallic ions. Bacteriological agar is the solidifying agent.
Chromogenic Agar Burkholderia Cepacia is a selective medium specially formulated for the isolation amd detection of Burkholderia cepacia.
Burkholderia cepacia is a bacterial species of rising importance in the pharmaceutical, OTC and cosmetic industries in recent years.
Burkholderia cepacia is a Gram-negative, oxidase positive, mobile and aerobic bacillus. It is normally found in water deposits and damp environments. This bacillus is an important opportunist pathogen and causes pulmonary infections in Cystic Fibrosis patients. The organism may be present in small numbers in many non sterile products used in hospitals. It has been isolated from a number of water sources and can grow in distilled water with a nitrogen source because of its capacity to fix CO2 from air.
The medium contains peptone, which provides nitrogen, vitamins, minerals, and amino acids essential for growth. Yeast extract is a source of vitamins, particularly of the B-group. Selective agents are added to improve B. cepacia recovery through the inhibition of common contaminants. Chromogenic
substrate is added to detect B. cepacia by means of a color change in its colonies. Bile salts inhibit most Gram-positive cocci except for enterococci.
Sodium pyruvate increases the recovery of stressed cells. Tween 80 and soya lecithin neutralize quaternary ammonium compounds and parahydroxy benzoates. Magnesium sulphate, ammonium sulphate, and ferroammonium citrate provide sources of sulfates and metallic ions. Bacteriological agar is the solidifying agent.
| Brand | CONDALAB |
|---|
Write Your Own Review

Validate your login